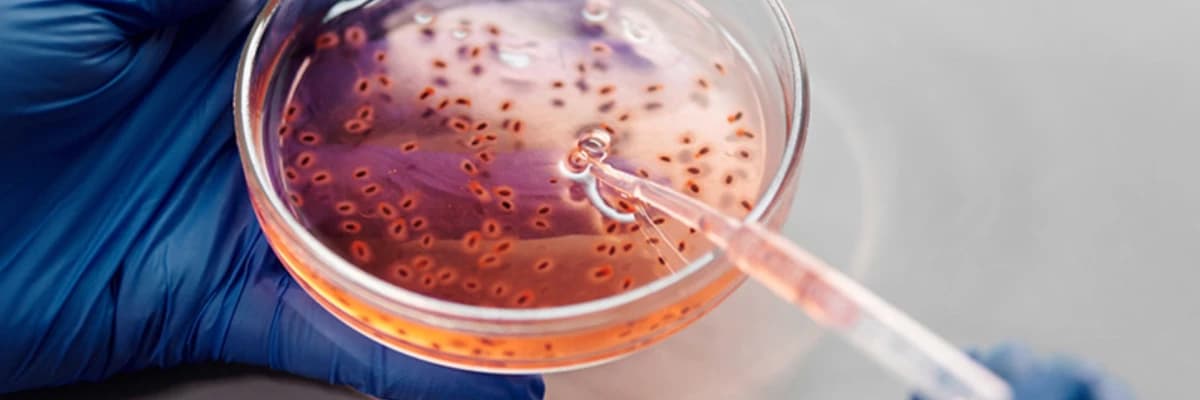
Oksidatif Stres Nedir ?

Oksidatif Stres Nedir ?
Dış etkiler ile vücuda alınan toksik maddelerin metabolize edilmesi sırasında ortayn çıkan serbest radikaller hücrede birçok fonksiyonel ve metabolik bozukluk ortaya çıkarır. Oluşan serbest radikaller, hücrelerin lipid, protein, DNA ve karbohidrat gibi tüm önemli yapılarına hasar verebilir. Serbest radikallerin vücutta yarattığı bu hasara “oksidatif hasar” denir. Serbest radikaller aynı zamanda normal hücre metabolik oksidasyonu sonucu bir yan ürün ve toksik atık olarak da ortaya çıkar. Antioksidanlar serbest radikalleri temizleyerek hücreleri oksidatif hasardan korur. Glutatyon vücudumuzda üretilen en güçlü “anti-oksidan” maddedir. Serbest radikalleri yakalayarak biriktirir ve karaciğerde etkisiz hale getirmede rol oynar. Glutatyon hücrelere hasar veren oksidatif strese, civa ve diğer toksik metallere, alkol ve vücutta biriken organik kirleticilere karşı koruyucu etki sağlar.
